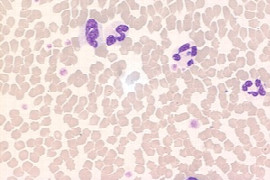

Hendrik Lehmann
Dipl. ACVECC

Hendrik Lehmann
Dipl. ACVECC
- Seit 2019: Oberarzt Intensivstation Klinik für Kleintiere der JLUGießen
- Juli &November 2018: Externship Emergency and Critical Care Service Vetsuisse Bern, CH
- November 2017: Externship Emergency and Critical Care Service Cornell, USA
- Oktober 2017: Teilnahme am ersten Cardiopulmonary Bootcamp Cornell University, NY, USA
- 2016-2018: Resident American College of Veterinary Emergency and Critical Care unter der Leitung von Frau Dr. med vet E. Haßdenteufel DACVECC, DECVECC
- 2014 - 2015: Rotating Internship an der Kleintierklinik der Vetmeduni Vienna, AT
- 2007 - 2014: Diplomstudium Vetmeduni Wien
Webinare

Henrik Wagner
DVM, FTA für kleine Wiederkäuer

Henrik Wagner
DVM, FTA für kleine Wiederkäuer
• Studium Agrarwissenschaften mit Schwerpunkt Tierproduktion von 1999 bis 2004 an der Justus-Liebig-Universität Gießen
• Promotion im Fachgebiet Tierzucht
• Parallelstudium der Veterinärmedizin, ebenfalls in Gießen.
• 2008 bis 2010 Wissenschaftlicher Mitarbeiter am Institut für Tierärztliche Nahrungsmittelkunde der Universität Gießen.
• Seit 2010 an der Klinik für Geburtshilfe, Gynäkologie und Andrologie der Groß- und Kleintiere, jetzt Tierklinik für Reproduktionsmedizin und Neugeborenenkunde, der Justus-Liebig-Universität Gießen als Tierarzt tätig
• Seit 2012 Leiter der Bestandsbetreuung kleiner Wiederkäuer und Neuweltkamelidenff
• Seit 2014 Fachtierarzt für kleine Wiederkäuer
• Seit 2021 Leitender Tierarzt des Schaf- und Ziegenherdengesundheitsdienstes Hessen an der JLU Gießen
• Seit 2022 Mitglied im Vorstand der Landestierärztekammer Hessen und Vorsitzender des Weiterbildungsausschuss
• Seit 2023 Mitglied im Tierschutzausschuss der JLU Gießen
• Seit 2023 Vorsitzender der DVG-Fachgruppe Kleine Wiederkäuer und Neuweltkamele
• Seit 2024 Mitglied Wiederkäuer-Ausschuss der Bundestierärztekammer (BTK)
Schwerpunkte:
• Arbeits- und Forschungsschwerpunkte sind die Reproduktion und Bestandsbetreuung kleiner Wiederkäuer und Neuweltkamele
Webinare

Herbert Auer
Univ.-Prof., DVM

Herbert Auer
Univ.-Prof., DVM
- Biologiestudium in Innsbruck (1978, Dr. phil.)
- 1979 – 1990: Assistent a. Hygiene-Institut d. Universität Wien
- Jänner 1991: Habilitation (Univ.-Doz.) für Med. Parasitologie
- seit 1997: ao. Univ.-Prof.
- seit 2004: Leiter d. Abt. für Med. Parasitologie an der Med. Universität Wien, zugleich Leiter des Österr. Referenzzentrums für Parasitosen
über 400 Publikationen, Review-Tätigkeit bei zahlreichen wissenschaftl. Journalen, wissenschaftliche Schwerpunkte: Epidemiologie und Labordiagnostik von Zoonosen, insbesondere von Helminthozoonosen (z. B. Echinokokkose, Toxokarose, Fasziolose, Toxoplasmose)
Webinare

Herwig Hampel
DVM

Herwig Hampel
DVM
Studium Veterinärmedizin in Wien
4 Jahre Assistent in verschiedenen Praxen
15 Jahre eigene Kleintierpraxis mit bis zu 5 Angestellten
Seit 14 Jahren bei IDEXX
Seit 6 Jahren Verkaufsleiter für Österreich
Seit 2 Jahren Verkaufsleiter auch für die Schweiz
Webinare

Holger A. Volk
Prof., Dip ECVN, PhD, PGCAP, FHEA, MRCVS

Holger A. Volk
Prof., Dip ECVN, PhD, PGCAP, FHEA, MRCVS
Holger Volk ist derzeit Professor für Kleintierkrankheiten und Leiter der Klinik für Kleintiere an der Tierärztlichen Hochschule Hannover. 2001 schloss er sein Studium an der Tierärztlichen Hochschule Hannover ab, wo er auch einen PhD erfolgreich abgeschlossen hatte, über Mechanismen der pharmakoresistenten Epilepsie. Anschließend schloss er seine klinische neurologische Ausbildung am Royal Veterinary College (RVC) ab und erhielt das Diplom des European College of Veterinary Neurology (ECVN).
Holger ist international bekannt für seine Arbeit im Bereich Corona-Spürhunde, neuropathische Schmerzen und Epilepsie. Er war Präsident des ECVN und im Executive Board of EBVS tätig. Holger war Vorsitzender der International Veterinary Epilepsy Task Force, war Co-Vorsitzender der veröffentlichten ACVIM-Konsenserklärung zur medizinischen Behandlung von Epilepsie und beteiligt für die Konsenserklärung über Bewegungsstörungen. Er wurde mit mehreren Jim Bee-Pädagogenauszeichnungen ausgezeichnet, dem renommierten Bourgelat Award der BSAVA, dem International Canine Health Award des Kennel Club und dem International Royal College of Veterinary Medicine Award. Er hat mehrere Bücher und Buchkapitel, >250 Artikel, >150 Konferenzabstracts veröffentlicht und ist ein bekannter Redner auf internationalen Konferenzen.
Webinare

Holger Uhlig
Dipl. Tzt.

Holger Uhlig
Dipl. Tzt.
- Geboren 1962
- Studium der Veterinärmedizin abgeschlossen 1991
- Seit 1992 tätig für Bayer Austria in versch. Funktionen
- Technical Service Manager & Regulatory Affairs Manager der Firma Bayer Austria (2015)
Webinare

Hubert Simhofer
Ass. Prof., DVM, Dipl. AVDC Eq, Dipl. EVDC Eq

Hubert Simhofer
Ass. Prof., DVM, Dipl. AVDC Eq, Dipl. EVDC Eq
1984-1992 Studium der Veterinärmedizin
1996 Promotion Dr. med. vet.
1996-2010 Universitätsassistent Vetmeduni Wien
2013 Diplomate American Veterinary Dental College (Dip. AVDC Eq)– Equine, Diplomate European Veterinary Dental College – Equine (Dip. EVDC Eq)
2015 Habilitation, AO Univ. Prof.
Seit 2020 freiberuflich tätig - Geschäftsführer der Pferdeklinik Gaaden GmbH
Webinare

Iain Keir
BVMS, Diplomate ACVECC

Iain Keir
BVMS, Diplomate ACVECC
I currently serve as Medical Director at AVETS, Pittsburgh, Pennsylvania and have done so for 4 years. Our hospital see’s 15,000 cases annually, 70% of which are seen by our Emergency and Critical Care team.
I graduated from the University of Glasgow, School of Veterinary Medicine in 2004 and subsequently complete a small animal internship at the Royal Veterinary College, London. After a couple of years in Emergency Practice, I completed an ECC Internship at Tuft University, Boston before returning to the Royal Veterinary College, London for an ECC residency from 2008-2011. I am board certified by both the American College of Veterinary Emergency and Critical Care and European College of Veterinary Emergency and Critical Care.
My research areas include the use of high flow nasal oxygen therapy and we have published the first series of articles documenting the use of this therapy in veterinary patients; in addition we are exploring methods of improving the use of low flow oxygen systems. My other areas of expertise is in organ dysfunction in sepsis and the role antibiotics play in limiting organ dysfunction and improving outcomes in patients with sepsis.
In August 2019, I will be moving to Sydney, Australia to serve as Head of Critical Care Medicine, at Small Animal Specialty Hospital (SASH).
Webinare

Ian Faux
BVMS, AFHEA, MSc, DipECVS, MRCVS

Ian Faux
BVMS, AFHEA, MSc, DipECVS, MRCVS
Ian is a Senior Lecturer in Small Animal Surgery. He graduated from the University of Glasgow in 2017 and spent one year in general practice before undertaking a rotating and surgical internship at the Hospital for Small Animals.
He went on to complete a residency in small animal surgery at the University of Edinburgh and has continued working there since.
He became a boarded diplomate of the European College of Veterinary Surgery in 2024. Ian's clinical interests include all aspects of small animal surgery and his research interests are in surgical safety and education.
Webinare

Ian Wright
DVM, BVMS, MSc, MRCVS, Chair of ESCCAP

Ian Wright
DVM, BVMS, MSc, MRCVS, Chair of ESCCAP
Ian is a practising Veterinary surgeon and co-owner of the Mount Veterinary Practice in Fleetwood. He has a master’s degree in veterinary parasitology and is chair of the European Scientific Counsel of Companion Animal Parasites (ESCCAP). Ian has over 130 published peer reviewed articles and papers and is an editorial board member for the Companion animal journal. He continues to carry out research in practice including work on intestinal nematodes and ticks.
Webinare

Ilka Emmerich
DVM, FTÄ für Pharmakologie und Toxikologie

Ilka Emmerich
DVM, FTÄ für Pharmakologie und Toxikologie
- 1990-1989 Studium der Veterinärmedizin in Leipzig
- Seit 1996 Mitarbeiterin am Institut für Pharmakologie, Pharmazie und Toxikologie an der Veterinärmedizinischen Fakultät der Universität Leipzig
- Seit 2002 Mitarbeit im Projekt VETIDATA (Veterinärmedizinischer Informationsdienst für Arzneimittelanwendung, Toxikologie und Arzneimittelrecht)
- 2004 Fachtierärztin für Pharmakologie und Toxikologie
- Vorsitzende des Ausschusses für Arzneimittel- und Futtermittelrecht der BTK und der mitteldeutschen Kammern
- Delegierte der Bundestierärztekammer
Webinare

Ina Schenk
DVM

Ina Schenk
DVM
1986 – 92 Studium und Approbation an der FU Berlin. Anschließend Promotion im Institut für Biochemie der DSHS Köln und der Universität Leipzig. Seit 1997 Wissenschaftliche Mitarbeiterin im Manfred-Donike Institut der DSHS Köln, (stellvertretende) Leitung der Abteilung Pferdedopinganalytik. Mitglied der AORC (Association of Racing Chemists) und des EHSLC (European Horserace Scientific Committe).
Webinare

DVM

DVM
Indra Fischer ist Tierärztin bei ROYAL CANIN und für den Bereich Corporate Affairs - Communication zuständig.
Webinare

Ingo Blanke
DVM

Ingo Blanke
DVM
Dr. Ingo Blanke ist Fachtierarzt für Kleintiere sowie für Zahnheilkunde der Kleintiere. Nach seinem Tiermedizinstudium in München promovierte er 2012 an der Medizinischen Kleintierklinik der LMU München zum Thema „Idiopathische Zystitis der Katze“.
2015 erlangte er die Anerkennung als Fachtierarzt für Kleintiere an der Tierklinik Oberhaching, wo er seit 2017 als Teilhaber tätig ist und zugleich das Kleintierzentrum Starnberg übernahm.
2023 folgte die Zusatzbezeichnung Fachtierarzt für Zahnheilkunde der Kleintiere. Dr. Blanke praktiziert in der Tierklinik Oberhaching bei München.
Webinare

Ingo Schäfer
DVM, M.Sc.

Ingo Schäfer
DVM, M.Sc.
Geboren in Karlsruhe 1986, Studium der Veterinärmedizin in Budapest und Berlin 2010-2016, Internship Kleintierklinik Freie Universität Berlin 2016-2018, seit 2018 wissenschaftlicher Mitarbeiter Kleintierklinik Freie Universität Berlin, Promotion 2019 im Bereich vektorübertragene Infektionen des Hundes, seit 2019 zusätzlich Tierarzt in der Abteilung für klinische Chemie bei LABOKLIN
Masterstudiengang “Master of Small Animal Science” mit Abschluss 2019
Schwerpunkte: vektorübertragene Infektionen, immunmediierte Erkrankungen bei Kleintieren